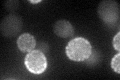
YNL194C
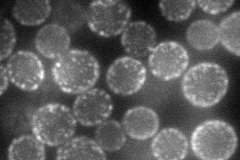
YNL194C
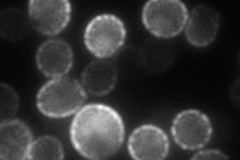
YNL194C
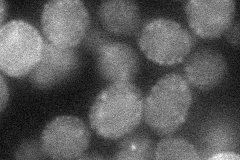
YNL194C
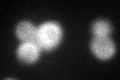
YNL194C

View description
Integral membrane protein required for sporulation and plasma membrane sphingolipid content; has sequence similarity to SUR7 and FMP45; GFP-fusion protein is induced in response to the DNA-damaging agent MMS
Localization:
Intensity:
Fold change:
Significance:
-
C’ GFP library in SD
cell periphery26.72 -
N' NOP1pr-GFP in SD
cell periphery,punctate63.091 -
N' TEF2pr-mCherry in SD
cell periphery,punctate81.4342 -
N' NATIVEpr-GFP in SD

cell periphery,punctate21.496 -
N' TEF2pr-VC and Cyto-VN in SD
cell periphery,punctate30.9755 -
C’ GFP library in SD+DTT
cell periphery34.871.3No -
C’ GFP library in SD+H2O2

cell periphery19.710.73Yes -
C’ GFP library in Starvation Media

cell periphery65.012.43Yes -
C’ GFP library on the background of Pup2-DaMP

cell periphery -
C’ GFP library on the background of CCT mutant

cell periphery25.52850.955054No
